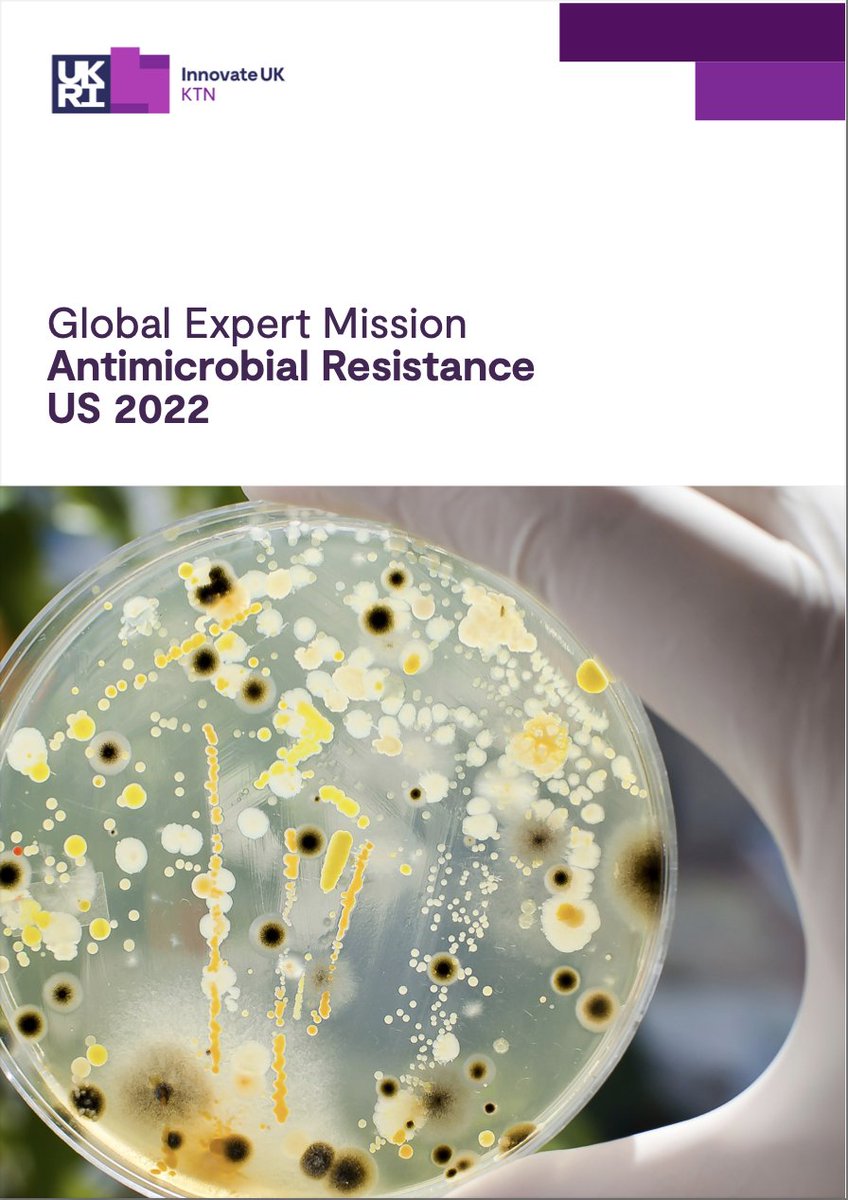
Yesterday we launched the report of our @KTNUK Global Expert Mission to the US on #OneHealth &amp; #AntimicrobialResistance - highlighting opportunities for UK-US collaboration in human #LifeSciences and #VeterinaryMedicine for improving #AMU and tackling the global threat of #AMR 🦠

The AMR & One Health Lab @QUB
@theamrlab
driving research into understanding and tackling antimicrobial resistance in microbiomes of living systems
ID: 1572978703432310787
22-09-2022 15:59:03
19 Tweet
57 Followers
40 Following





Great kick off today of the Great CART Project Lots of engaging visitors and interaction. As always Microbiology Society supported the event! Thanks to everyone who have supplied our first set of samples. Get in touch to take part!


Wonderful team, Lots of engagement, interactive games and curios minds during Great CART Project #NISF23 Queen's University Belfast today. Find out more and join the fight against #amr lnkd.in/e4qa7kND

Fancy making a contribution to our scientific understanding of one the most challenging issues in Animal Science? We have a funded PhD position on bovine mastitis with Dr Orla Keane of Teagasc & UCD School Ag & Food. Exciting training in microbiology, immunology and genomics! Please RT.


Pictured is Year 13 student Salma from Victoria College on her Nuffield Foundation #experience placement under the supervision of the lovely Linda Oyama The AMR & One Health Lab @QUB 🥼👏🌠Thank you for taking part Salma and we hope you enjoyed the #NEP programme🤩More to follow💁♂️


Very proud of this achievement Dr Simon Doherty Congratulations 👏🎉

We are delighted to have finally made it to Microbiology Society #Microbio24 Conference in Edinburgh! As always an electrifying and warm atmosphere. Looking forward to the first full day tomorrow Gama Dominic mustasim famous Linda Oyama


If you're at Microbiology Society #Microbio24 Conference in Edinburgh. Stop by and check out our posters! Gama Dominic mustasim famous Linda Oyama


I am looking for a motivated PDRA to join the lab UoB Biosciences to work on methanotrophs in lakes. it's a 4 year position, deadline 15th April. edzz.fa.em3.oraclecloud.com/hcmUI/Candidat…

Fascinating talk with many nuggets of wisdom by Lucy Thorne, Winner of Microbiology Society #Microbio24 Peter Wildy Prize. Well deserved!!


Our research at The AMR & One Health Lab @QUB is contributing to finding solutions to this urgent global threat. #AMR